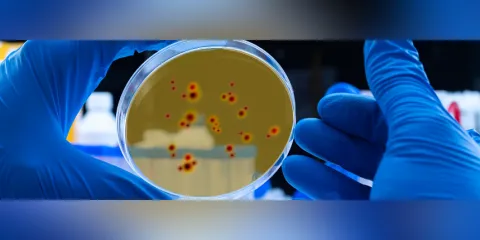

Cada año el mundo recibe alertas por emergencias sanitarias y sin superar los grandes efectos que provocó la pandemia del Covid-19 en el año 2020. La Organización Mundial de la Salud anunció que a inicios del mes de mayo de 2022 se ha detectado la propagación de una enfermedad que no es nueva, pero de la que no se ha oído hablar: la viruela del mono. Es así, como Luis Carlos Villamil Jiménez, docente investigador de la Facultad de Ciencias Agropecuarias de la Universidad de La Salle y experto en el tema nos cuenta de qué se trata.
Este tipo de viruela es considerada como una enfermedad zoonótica viral lo que significa que puede transmitirse de animales a humanos y también se puede propagar de persona a persona. Se denomina así “porque apareció en una colonia de primates para la experimentación de monos en un país escandinavo en 1958. Desde 1968, se habían presentado brotes en países africanos, pero, en el 2003 apareció en los Estados Unidos al parecer por contacto con perros de las praderas que habían permanecido en contacto con roedores traídos de África en una tienda de mascotas, pero desde entonces no se había vuelto a escuchar”, afirma el Dr. Villamil.
Lo curioso es que se está presentando una epidemia en países europeos, también en Australia, Israel, Argentina, Estados Unidos, Canadá y Brasil y como tal la fuente de infección no se conoce con exactitud. Según la OMS, “los síntomas generalmente son: fiebre, dolor de cabeza intenso, dolores musculares, dolor de espalda, poca energía, ganglios linfáticos inflamados y erupciones o lesiones en la piel. La erupción comienza en el primer o tercer día del comienzo de la fiebre y tiende a presentarse en la cara, las palmas de las manos y las plantas de los pies. También se pueden encontrar en la boca, los genitales y los ojos”.
Sin embargo, “esta viruela por ser un virus DNA, es estable y no se crean muchas variantes. Es así como se determina que solo hay dos variantes de esta viruela una de África Central y otra de África Occidental esta es menos virulenta y es la causante del brote actual. De acuerdo con la OMS la epidemia de viruela del mono no parece tener la severidad de la pandemia por Covid-19”, aclara el Dr. Villamil.